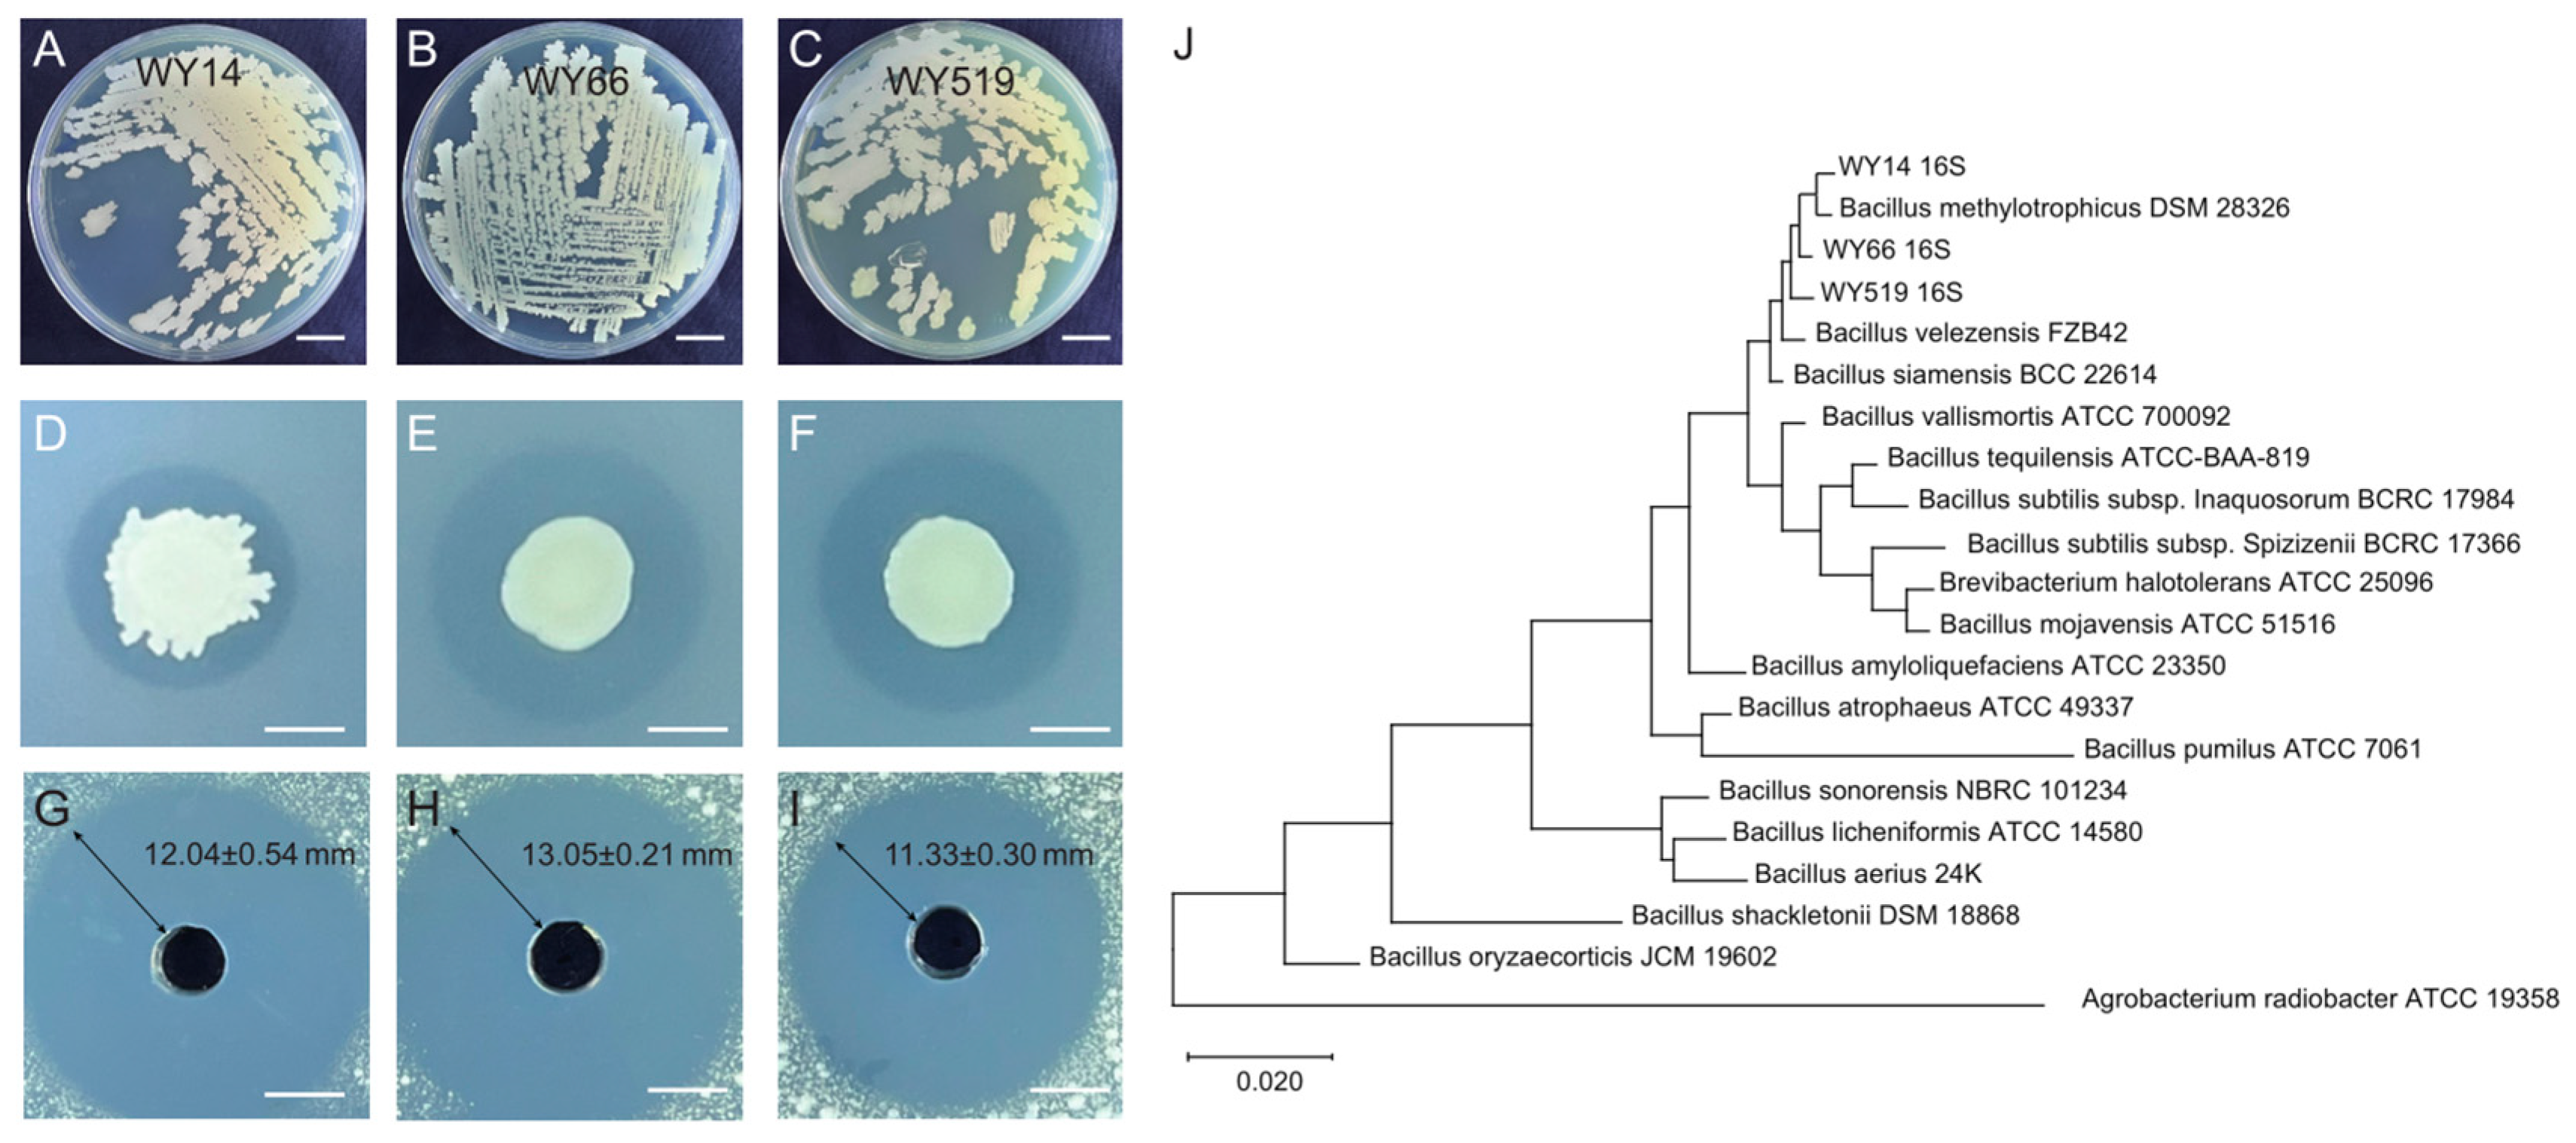
Plants 14 00475 g001

Biocontrol of Crown Gall Disease of Cherry Trees by Bacillus velezensis
Abstract
1. Introduction
2. Materials and Methods
2.1. Isolates and Strains
2.2. Phylogenetic Test
2.3. Antagonism Assay Between Biocontrol Bacteria and Pathogens
2.4. Biological Assay
2.5. Amplification of the Surfactin Synthesis Gene Sequence
2.6. RT-PCR
2.7. Enzyme Activity Assay
2.8. Statistical Analysis
3. Results
3.1. Three Bacillus Strains Inhibiting the Growth of Agrobacterium Were Isolated
3.2. Biocontrol Effect of Antagonistic Bacteria on CGD in Potted Cherry Seedlings
3.3. The Bacillus Strains Produce Antibiotics That May Inhibit A. tumefaciens
3.4. Inoculation with the Bacillus Strains Triggers Plant ISR
3.5. No Significant Change Is Detected in the Oxidase Activities of Plants When Inoculated by the Bacillus Strains
4. Discussion
Author Contributions
Funding
Data Availability Statement
Conflicts of Interest
Abbreviations
References
- Das, A. DNA transfer from Agrobacterium to plant cells in crown gall tumor disease. Subcell. Biochem. 1998, 29, 343–363. [Google Scholar] [CrossRef] [PubMed]
- Hooykaas, P.J.J. The Ti Plasmid, Driver of Agrobacterium Pathogenesis. Phytopathology 2023, 113, 594–604. [Google Scholar] [CrossRef]
- Chilton, M.D.; Drummond, M.H.; Merio, D.J.; Sciaky, D.; Montoya, A.L.; Gordon, M.P.; Nester, E.W. Stable incorporation of plasmid DNA into higher plant cells: The molecular basis of crown gall tumorigenesis. Cell 1977, 11, 263–271. [Google Scholar] [CrossRef] [PubMed]
- Gohlke, J.; Deeken, R. Plant responses to Agrobacterium tumefaciens and crown gall development. Front. Plant Sci. 2014, 5, 155. [Google Scholar] [CrossRef]
- Tiwari, M.; Mishra, A.K.; Chakrabarty, D. Agrobacterium-mediated gene transfer: Recent advancements and layered immunity in plants. Planta 2022, 256, 37. [Google Scholar] [CrossRef] [PubMed]
- Benjama, A.; Boubaker, A.; Khlief, H.; Krimi, Z.; Nesme, X.; Lopez, M.; Zoina, A. Susceptibility of stone-fruit rootstocks, rose and grapevine to Agrobacterium radiobacter var. tumefaciens in Arab Mediterranean countries. Bull. OEPP 2002, 32, 463–466. [Google Scholar] [CrossRef]
- Horuz, S.; Caglar, B.K.; Kusek, M.; Aysan, Y. Crown Gall Disease Susceptibility of Some Stone Fruit Rootstocks in Turkey. J. Agric. Sci.-Tarim. Bilim. Derg. 2018, 24, 439–444. [Google Scholar] [CrossRef]
- Oksel, C.; Liyanapathiranage, P.; Parajuli, M.; Avin, F.A.; Jennings, C.; Simmons, T.; Baysal-Gurel, F. Evaluation of Chemical and Biological Products for Control of Crown Gall on Rose. Pathogens 2024, 13, 708. [Google Scholar] [CrossRef]
- Pulawska, J. Crown gall on stone fruit trees. In Proceedings of the 2nd International Workshop on Bacterial Diseases of Stone Fruits and Nuts, Izmir, Turkey, 21–24 April 2015. [Google Scholar]
- Liang, C.; Wan, T.; Wu, R.; Zhao, M.; Zhao, Y.; Cai, Y. Resistance analysis of cherry rootstock ‘CDR-1’ (Prunus mahaleb) to crown gall disease. BMC Plant Biol. 2020, 20, 516. [Google Scholar] [CrossRef]
- Wang, H.; Sui, X.; Li, J.; Dai, X.; Ma, D. Isolation and identification of Agrobacterium spp. from cherry crown galls and their sensitivities to agrocin 84. Wei Sheng Wu Xue Bao 1998, 38, 381–385. [Google Scholar]
- Utkhede, R.S.; Smith, E.M. Evaluation of Biological and Chemical Treatments for Control of Crown Gall on Young Apple Trees in the Kootenay Valley of British Columbia. J. Phytopathol. 2008, 137, 265–271. [Google Scholar] [CrossRef]
- Kawaguchi, A. Biological control of crown gall on grapevine and root colonization by nonpathogenic Rhizobium vitis strain ARK-1. Microbes Environ. 2013, 28, 306–311. [Google Scholar] [CrossRef] [PubMed]
- Kawaguchi, A.; Inoue, K.; Ichinose, Y. Biological control of crown gall of grapevine, rose, and tomato by nonpathogenic Agrobacterium vitis strain VAR03-1. Phytopathology 2008, 98, 1218–1225. [Google Scholar] [CrossRef] [PubMed][Green Version]
- Kawaguchi, A.; Inoue, K.; Tanina, K. Evaluation of the Nonpathogenic Agrobacterium vitis Strain ARK-1 for Crown Gall Control in Diverse Plant Species. Plant Dis. 2015, 99, 409–414. [Google Scholar] [CrossRef] [PubMed]
- Meena, M.; Swapnil, P.; Divyanshu, K.; Kumar, S.; Harish; Tripathi, Y.N.; Zehra, A.; Marwal, A.; Upadhyay, R.S. PGPR-mediated induction of systemic resistance and physiochemical alterations in plants against the pathogens: Current perspectives. J. Basic Microbiol. 2020, 60, 828–861. [Google Scholar] [CrossRef] [PubMed]
- Nagrale, D.T.; Chaurasia, A.; Kumar, S.; Gawande, S.P.; Hiremani, N.S.; Shankar, R.; Gokte-Narkhedkar, N.; Renu; Prasad, Y.G. PGPR: The treasure of multifarious beneficial microorganisms for nutrient mobilization, pest biocontrol and plant growth promotion in field crops. World J. Microbiol. Biotechnol. 2023, 39, 100. [Google Scholar] [CrossRef] [PubMed]
- Santoyo, G.; Urtis-Flores, C.A.; Loeza-Lara, P.D.; Orozco-Mosqueda, M.D.C.; Glick, B.R. Rhizosphere Colonization Determinants by Plant Growth-Promoting Rhizobacteria (PGPR). Biology 2021, 10, 475. [Google Scholar] [CrossRef]
- Paterson, J.; Jahanshah, G.; Li, Y.; Wang, Q.; Mehnaz, S.; Gross, H. The contribution of genome mining strategies to the understanding of active principles of PGPR strains. FEMS Microbiol. Ecol. 2017, 93, fiw249. [Google Scholar] [CrossRef]
- Liu, Y.; Han, S.; Song, L.; Li, L.; Wang, H.; Pan, M.; Tan, J. Screening of bacterial endophytes of larch against Neofusicoccum laricinum and validation of their safety. Microbiol. Spectr. 2024, 12, e04112-23. [Google Scholar] [CrossRef] [PubMed]
- Ben Gharsa, H.; Bouri, M.; Mougou Hamdane, A.; Schuster, C.; Leclerque, A.; Rhouma, A. Bacillus velezensis strain MBY2, a potential agent for the management of crown gall disease. PLoS ONE 2021, 16, e0252823. [Google Scholar] [CrossRef] [PubMed]
- Cochrane, S.A.; Vederas, J.C. Lipopeptides from Bacillus and Paenibacillus spp.: A Gold Mine of Antibiotic Candidates. Med. Res. Rev. 2016, 36, 4–31. [Google Scholar] [CrossRef]
- Fira, D.; Dimkić, I.; Berić, T.; Lozo, J.; Stanković, S. Biological control of plant pathogens by Bacillus species. J. Biotechnol. 2018, 285, 44–55. [Google Scholar] [CrossRef]
- Piewngam, P.; Zheng, Y.; Nguyen, T.H.; Dickey, S.W.; Joo, H.S.; Villaruz, A.E.; Glose, K.A.; Fisher, E.L.; Hunt, R.L.; Li, B.; et al. Pathogen elimination by probiotic Bacillus via signalling interference. Nature 2018, 562, 532–537. [Google Scholar] [CrossRef] [PubMed]
- Pan, M.; Xu, J.; Han, S.; Sun, Y.; Tan, J. Effects of Bacillus cereus NJSZ-13 on Fatty Acid Metabolism of Bursaphelenchus xylophilus. Forests 2023, 14, 2065. [Google Scholar] [CrossRef]
- Farag, M.A.; Zhang, H.; Ryu, C.M. Dynamic chemical communication between plants and bacteria through airborne signals: Induced resistance by bacterial volatiles. J. Chem. Ecol. 2013, 39, 1007–1018. [Google Scholar] [CrossRef] [PubMed]
- Grady, E.N.; MacDonald, J.; Liu, L.; Richman, A.; Yuan, Z.C. Current knowledge and perspectives of Paenibacillus: A review. Microb. Cell Factories 2016, 15, 203. [Google Scholar] [CrossRef] [PubMed]
- Khan, A.R.; Mustafa, A.; Hyder, S.; Valipour, M.; Rizvi, Z.F.; Gondal, A.S.; Yousuf, Z.; Iqbal, R.; Daraz, U. Bacillus spp. as Bioagents: Uses and Application for Sustainable Agriculture. Biology 2022, 11, 1763. [Google Scholar] [CrossRef]
- Beneduzi, A.; Ambrosini, A.; Passaglia, L.M. Plant growth-promoting rhizobacteria (PGPR): Their potential as antagonists and biocontrol agents. Genet. Mol. Biol. 2012, 35, 1044–1051. [Google Scholar] [CrossRef]
- Zhu, L.; Huang, J.; Lu, X.; Zhou, C. Development of plant systemic resistance by beneficial rhizobacteria: Recognition, initiation, elicitation and regulation. Front. Plant Sci. 2022, 13, 952397. [Google Scholar] [CrossRef] [PubMed]
- Kavutu, A.M.; Mwangi, M.; Kahuthia-Gathu, R.; Wanjohi, W. Application of antagonistic bacteria in management of crown gall disease on roses in Kenya. In Proceedings of the 31st International Horticultural Congress (IHC)—Horticulture for a World in Transition/International Symposium on Sustainable Control of Pests and Diseases, Angers, France, 14–20 August 2022. [Google Scholar]
- Rhouma, A.; Bouri, M.; Boubaker, A.; Nesme, X. Potential effect of rhizobacteria in the management of crown gall disease caused by agrobacterium tumefaciens biovar 1. J. Plant Pathol. 2008, 90, 517–526. [Google Scholar]
- Yan, P.; Zhang, X.-T.; Hu, L.-J.; Wang, Y.-H.; Zhu, M.-L.; Wu, X.-Q.; Chen, F. Two novel strains, Bacillus albus JK-XZ3 and B. velezensis JK-XZ8, with activity against Cerasus crown gall disease in Xuzhou, China. Australas Plant Pathol. 2020, 49, 127–136. [Google Scholar] [CrossRef]
- Kim, W.I.; Cho, W.K.; Kim, S.N.; Chu, H.; Ryu, K.Y.; Yun, J.C.; Park, C.S. Genetic diversity of cultivable plant growth-promoting rhizobacteria in Korea. J. Microbiol. Biotechnol. 2011, 21, 777–790. [Google Scholar] [CrossRef] [PubMed]
- Yao, B.; Zhang, J.-H.; He, Y.-L.; Liang, X.-Q.; Cui, X.-G.; Rong, L.-F.; Zhou, X.-H.; Wei, F.-J.; He, Z.-L.; Ji, G.-H.; et al. Study on biocontrol mechanism of Bacillus amyloliquefaciens JK10 to control blueberry crown gall disease. Chin. J. Biol. Control 2022, 38, 613–625. [Google Scholar] [CrossRef]
- Sunita, R.; Saleena, L.M.; Vasudevan, P.; Nair, S. Biological suppression of rice diseases by Pseudomonas spp. under saline soil conditions. Plant Soil 2003, 251, 73–82. [Google Scholar] [CrossRef]
- Kuzmanović, N.; Puławska, J.; Hao, L.; Burr, T.J. The Ecology of Agrobacterium vitis and Management of Crown Gall Disease in Vineyards. Curr. Top. Microbiol. Immunol. 2018, 418, 15–53. [Google Scholar] [CrossRef] [PubMed]
- Chen, X.H.; Scholz, R.; Borriss, M.; Junge, H.; Mögel, G.; Kunz, S.; Borriss, R. Difficidin and bacilysin produced by plant-associated Bacillus amyloliquefaciens are efficient in controlling fire blight disease. J. Biotechnol. 2009, 140, 38–44. [Google Scholar] [CrossRef] [PubMed]
- Han, X.; Shen, D.; Xiong, Q.; Bao, B.; Zhang, W.; Dai, T.; Zhao, Y.; Borriss, R.; Fan, B. The Plant-Beneficial Rhizobacterium Bacillus velezensis FZB42 Controls the Soybean Pathogen Phytophthora sojae Due to Bacilysin Production. Appl. Environ. Microbiol. 2021, 87, e0160121. [Google Scholar] [CrossRef]
- Chen, L.; Wang, X.; Liu, Y. Contribution of macrolactin in Bacillus velezensis CLA178 to the antagonistic activities against Agrobacterium tumefaciens C58. Arch. Microbiol. 2021, 203, 1743–1752. [Google Scholar] [CrossRef]
- Pandey, C.; Prabha, D.; Negi, Y.K.; Maheshwari, D.K.; Dheeman, S.; Gupta, M. Macrolactin A mediated biocontrol of Fusarium oxysporum and Rhizoctonia solani infestation on Amaranthus hypochondriacus by Bacillus subtilis BS-58. Front. Microbiol. 2023, 14, 1105849. [Google Scholar] [CrossRef]
- Yousfi, S.; Krier, F.; Deracinois, B.; Steels, S.; Coutte, F.; Frikha-Gargouri, O. Characterization of Bacillus velezensis 32a metabolites and their synergistic bioactivity against crown gall disease. Microbiol. Res. 2024, 280, 127569. [Google Scholar] [CrossRef]
- Fan, B.; Li, Y.L.; Mariappan, A.; Becker, A.; Wu, X.Q.; Borriss, R. New SigD-regulated genes identified in the rhizobacterium Bacillus amyloliquefaciens FZB42. Biol. Open 2016, 5, 1776–1783. [Google Scholar] [CrossRef]
- Koumoutsi, A.; Chen, X.H.; Henne, A.; Liesegang, H.; Hitzeroth, G.; Franke, P.; Vater, J.; Borriss, R. Structural and functional characterization of gene clusters directing nonribosomal synthesis of bioactive cyclic lipopeptides in Bacillus amyloliquefaciens strain FZB42. J. Bacteriol. 2004, 186, 1084–1096. [Google Scholar] [CrossRef] [PubMed]
- Al-Ali, A.; Deravel, J.; Krier, F.; Béchet, M.; Ongena, M.; Jacques, P. Biofilm formation is determinant in tomato rhizosphere colonization by Bacillus velezensis FZB42. Environ. Sci. Pollut. Res. Int. 2018, 25, 29910–29920. [Google Scholar] [CrossRef]
- Sahu, P.K.; Jayalakshmi, K.; Tilgam, J.; Gupta, A.; Nagaraju, Y.; Kumar, A.; Hamid, S.; Singh, H.V.; Minkina, T.; Rajput, V.D.; et al. ROS generated from biotic stress: Effects on plants and alleviation by endophytic microbes. Front. Plant Sci. 2022, 13, 1042936. [Google Scholar] [CrossRef] [PubMed]

| Antibiotic | Sequence (5′-3′) | Expected Amplified Fragment Length | Positive Control |
|---|---|---|---|
| difficidin | dfnMF1: CGGAGTGAAACCGTGCCGGGATAAAGA; | ~1300 | B. velezensis FZB42 |
| dfnMR1: GACCATTCAGAGCGGAAAGCTCC | |||
| bacilysin | bacC1: GGAAACCGCCGTTTACGTTC; | ~1500 | B. velezensis FZB42 |
| bacC2: CCATGAGGCACACGAAGAGA | |||
| macrolactin | mlnIF1: GGAAGAAAAACAGTCGAGGCGATGCTG; | ~1300 | B. velezensis FZB42 |
| mlnIR1: GAGAAGCTCCGCCGTCACCAGTG |
| Name | Sequence (5′-3′) | Gene Product |
|---|---|---|
| RmACT-F | TACAACTGGTATTGTCCTGGAC | actin |
| RmACT-R | TCATGTCCCTGACTATTTCTCG | |
| RmERF1-F | GATCGCAACCGGTTAGAATAAC | ethylene-responsive transcription factor 1 |
| RmERF1-R | CTCGTCTCAACCATCTCTACTC | |
| RmPR1-F | CAGTGTGAACTTCTTACGGTTC | pathogenesis-related protein 1 |
| RmPR1-R | TTGCTACGAGTTCATACTGTGT | |
| RmPR2-F | AATCAAAGTTTCCACAGCCATC | b-1,3-glucanase |
| RmPR2-R | GAAGAGAGCATAATCGAGACGA | |
| RmPR3-F | TGGGGTTATTGCTTTGTCAATG | basic chitinase |
| RmPR3-R | GGTTTGTTTGATTGTGGAGTCA | |
| RmPR4-F | GGAAAACAATGCGTCGTGTTTT | hevein-like protein |
| RmPR4-R | TCTCACGTTAGTAGCACTTTGT | |
| RmAOS-F | ACTACCAGAGACTCTACGACTT | allene oxide synthase |
| RmAOS-R | TGGGAAATAAAAGCTTCATGCC | |
| RmMYC2-F | TTCAACCAGGAGACGCTTATG | transcription factor MYC2 |
| RmMYC2-R | CGGAAATCAAAGAGTTGAGGTC |
| Treatment | Inoculum Size (CFU/mL) | Dead | Survival | Mortality of Group (%) | Mean Diameter of Galls (mm) | Disease Index | Biocontrol Efficiency (%) |
|---|---|---|---|---|---|---|---|
| CK | - | 11 | 4 | 73.33 | 38.4 ± 8.77 a | 3.85 | - |
| WY14 | 107 | 4 | 11 | 26.67 | 17.03 ± 5.21 bc | 2 | 69.43% |
| 108 | 0 | 15 | 0.00 | 20.36 ± 4.90 b | 1.33 | 100% | |
| 109 | 0 | 15 | 0.00 | 6.93 ± 1.33 c | 0.67 | 100% | |
| WY66 | 107 | 2 | 13 | 13.33 | 19.1 ± 6.08 b | 1.67 | 84.73% |
| 108 | 0 | 15 | 0.00 | 13.93 ± 5.67 bc | 1.33 | 100% | |
| 109 | 0 | 15 | 0.00 | 6.7 ± 2.20 c | 0.33 | 100% | |
| WY519 | 107 | 2 | 13 | 13.33 | 18.33 ± 7.10 bc | 1.67 | 84.73% |
| 108 | 0 | 15 | 0.00 | 28.86 ± 9.14 ab | 2.66 | 100% | |
| 109 | 0 | 15 | 0.00 | 16.3 ± 5.23 bc | 1.33 | 100% |
Disclaimer/Publisher’s Note: The statements, opinions and data contained in all publications are solely those of the individual author(s) and contributor(s) and not of MDPI and/or the editor(s). MDPI and/or the editor(s) disclaim responsibility for any injury to people or property resulting from any ideas, methods, instructions or products referred to in the content. |
© 2025 by the authors. Licensee MDPI, Basel, Switzerland. This article is an open access article distributed under the terms and conditions of the Creative Commons Attribution (CC BY) license (https://creativecommons.org/licenses/by/4.0/).
Share and Cite
Li, Y.; Gao, Z.; Kong, W.; Xiao, Y.; Adjei, M.O.; Fan, B. Biocontrol of Crown Gall Disease of Cherry Trees by Bacillus velezensis. Plants 2025, 14, 475. https://doi.org/10.3390/plants14030475
Li Y, Gao Z, Kong W, Xiao Y, Adjei MO, Fan B. Biocontrol of Crown Gall Disease of Cherry Trees by Bacillus velezensis. Plants. 2025; 14(3):475. https://doi.org/10.3390/plants14030475
Chicago/Turabian StyleLi, Yongfeng, Zhaoliang Gao, Weiliang Kong, Yueting Xiao, Mark Owusu Adjei, and Ben Fan. 2025. "Biocontrol of Crown Gall Disease of Cherry Trees by Bacillus velezensis" Plants 14, no. 3: 475. https://doi.org/10.3390/plants14030475
APA StyleLi, Y., Gao, Z., Kong, W., Xiao, Y., Adjei, M. O., & Fan, B. (2025). Biocontrol of Crown Gall Disease of Cherry Trees by Bacillus velezensis. Plants, 14(3), 475. https://doi.org/10.3390/plants14030475

